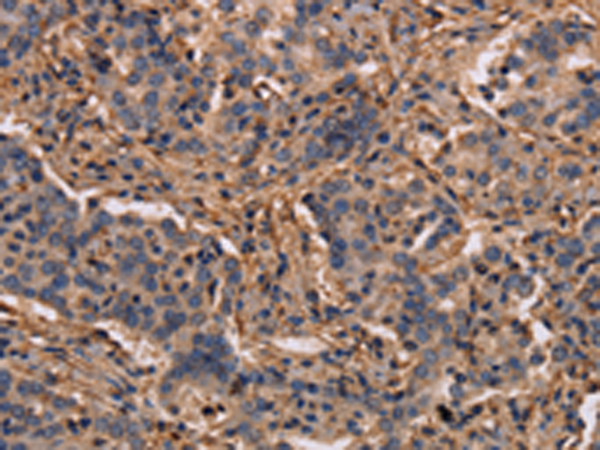

-
分类: 科研抗体货号: P05015别名: LC3C; ATG8J应用: IHC反应种属: Human
-
分类: 科研抗体货号: P05013别名: Trh4; LASS5应用: IHC反应种属: Human, Mouse
-
分类: 科研抗体货号: P05078别名: BIRC1; NLRB1; psiNAIP应用: IHC反应种属: Human
-
分类: 科研抗体货号: P05012别名: Trh1; LASS4应用: WB,IHC反应种属: Human
-
分类: 科研抗体货号: P05138别名: IRT1; ARTD3; ADPRT3; ADPRTL2; ADPRTL3; PADPRT-3应用: WB,IHC反应种属: Human
-
分类: 科研抗体货号: P05075别名: P160; PAP2应用: WB,IHC反应种属: Human
-
分类: 科研抗体货号: P05011别名: EPM8; GDF1; LAG1; UOG1; GDF-1; LASS1应用: WB反应种属: Human, Mouse
-
分类: 科研抗体货号: P05136别名: JM27; JM-27; CT16.7; GAGE-9; GAGEC1; PAGE-1; PAGE-4应用: IHC反应种属: Human
-
分类: 科研抗体货号: P05073别名: MIM; MIMA; MIMB应用: IHC反应种属: Human, Mouse
-
分类: 科研抗体货号: P05000别名: KIF3X; KLP-2; OSM-3; KIF17B应用: IHC反应种属: Human

鄂公网安备42018502007531号
鄂公网安备42018502007531号

